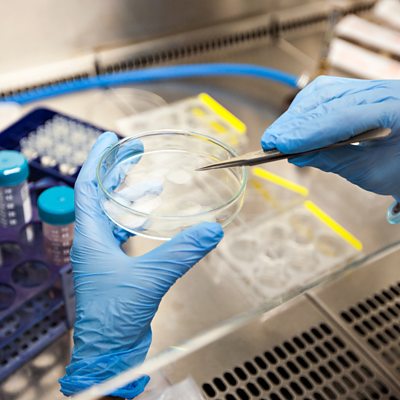

Episode details
Available for over a year
Unproven and unlicensed stem cell therapies for Covid-19 are being marketed by a number of small companies in the United States. Bioethicist Leigh Turner of the University of Minnesota tracks the questionable claims and safety record of this direct-to-consumer sector of the biotech market. He says he is concerned that in the current climate of coronavirus anxiety, more people will be vulnerable to wasting thousands of dollars on treatments that do not work and may put their health at risk. Also in the programme, Jennifer O’Mahony reports on why Spanish health workers have suffered the highest coronavirus infection rate of all countries publishing this statistic: 20% in Spain, compared to 10% in Italy and 3% in the United States. Claudia talks to psychologists in China and the USA about how the wearing of face masks affects the way we communicate with other each. BBC health and science correspondent James Gallagher is on hand to talk about stem cells, the global eradication of both small pox and the coronavirus, and a fungus that might be harnessed in the control of malaria. Presenter: Claudia Hammond Producer: Andrew Luck-Baker (Picture: A microbiologist working in a laboratory. Photo credit: gevende/Getty Images.)
Programme Website